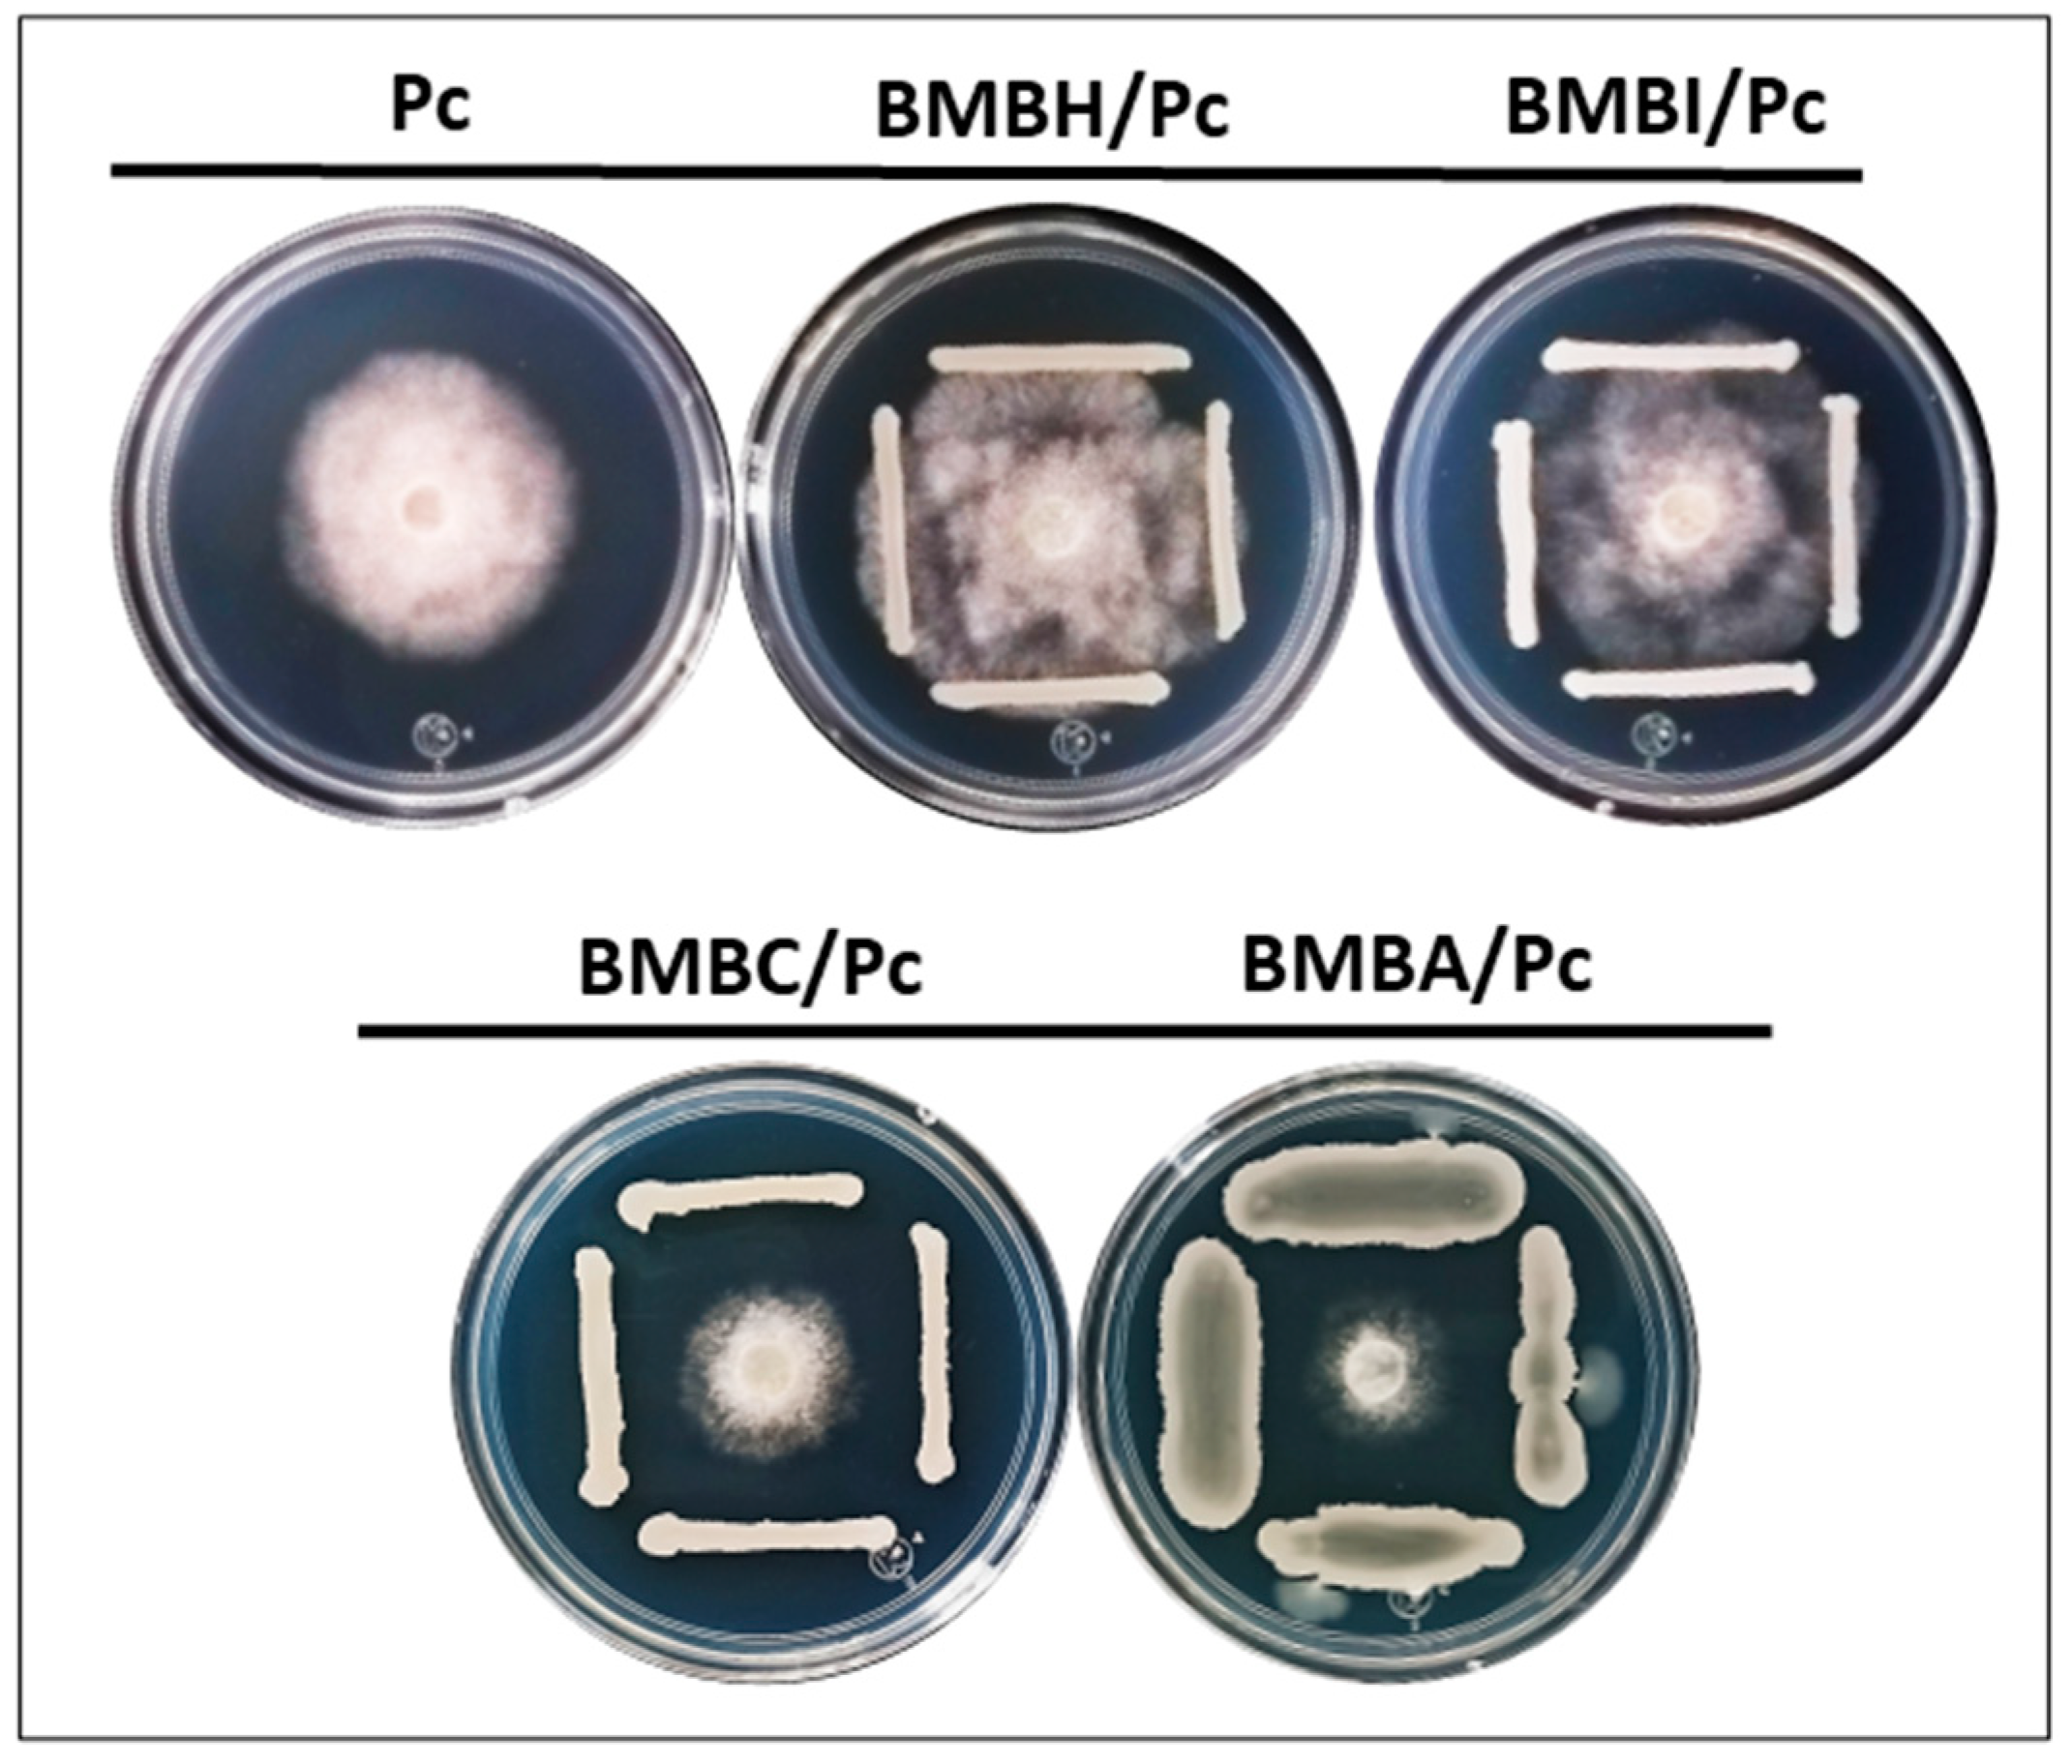
Plants 13 03224 g001

Antagonistic Effects and Volatile Organic Compound Profiles of Rhizobacteria in the Biocontrol of Phytophthora capsici
Abstract
1. Introduction
2. Results
2.1. In Vitro Antagonistic Activity
2.2. Morphological Analysis and Sporangia Quantification
2.3. Severity Analysis
2.4. Volatile Organic Compounds (VOCs) During Rhizobacteria-P. capsici Interaction
3. Discussion
4. Materials and Methods
4.1. Microbiological Material
4.2. In Vitro Antagonistic Activity Assays
4.2.1. Dual Culture Assays
4.2.2. Morphological Alterations in P. capsici Mycelium
4.3. Morphometric and Pathogenicity Analysis
4.3.1. Sporangium Induction and Quantification
4.3.2. Microscopic Morphometric Analysis
4.3.3. Detached Leaf Assay for Pathogenicity
4.4. Qualitative and Quantitative Analysis of Volatile Organic Compounds (VOCs)
4.4.1. VOC Collection from Bacterial and Dual Cultures
4.4.2. VOCs Extraction Using HS-SPME
4.4.3. VOC Analysis Using GC/MS
4.4.4. Identification and Quantification of VOCs
4.4.5. Validation of the Analytical Method
4.5. Statistical Analysis
5. Conclusions
Author Contributions
Funding
Data Availability Statement
Acknowledgments
Conflicts of Interest
References
- Olatunji, T.L.; Afolayan, A.J. The suitability of chili pepper (Capsicum annuum L.) for alleviating human micronutrient dietary deficiencies: A review. Food Sci. Nutr. 2018, 6, 2239–2251. [Google Scholar] [CrossRef] [PubMed]
- Hernández-Pérez, T.; Gómez-García, M.d.R.; Valverde, M.E.; Paredes-López, O. Capsicum annuum (hot pepper): An ancient Latin-American crop with outstanding bioactive compounds and nutraceutical potential. A review. Compr. Rev. Food Sci. Food Saf. 2020, 19, 2972–2993. [Google Scholar] [CrossRef] [PubMed]
- Oelke, L.M. Differentiation of Race Specific Resistance to Phytophthora Root Rot and Foliar Blight in Capsicum annuum; New Mexico State University: Las Cruces, NM, USA, 2001. [Google Scholar]
- Volynchikova, E.; Kim, K.D. Biological control of oomycete soilborne diseases caused by Phytophthora capsici, Phytophthora infestans, and Phytophthora nicotianae in solanaceous crops. Mycobiology 2022, 50, 269–293. [Google Scholar] [CrossRef] [PubMed]
- Lamour, K.H.; Stam, R.; Jupe, J.; Huitema, E. The oomycete broad-host-range pathogen Phytophthora capsici. Mol. Plant Pathol. 2012, 13, 329–337. [Google Scholar] [CrossRef] [PubMed]
- Siddique, M.I.; Khin Pa Pa Wai, K.P.P.W.; Mo HwangSung, M.H.; Yoo HeeJu, Y.H.; Jang KilSu, J.K.; Jeon SuGyeong, J.S.; Hwang JiEun, H.J.; Kim ByungSoo, K.B. Resistance to Phytophthora capsici, restorer-of-fertility genotype for cytoplasmic male sterility and chemical quality components of breeding lines developed for improvement of Subicho, a land race of pepper in Yeongyang. Hortic. Sci. Technol. 2017, 35, 758–768. [Google Scholar]
- Granke, L.; Windstam, S.; Hoch, H.; Smart, C.; Hausbeck, M. Dispersal and movement mechanisms of Phytophthora capsici sporangia. Phytopathology 2009, 99, 1258–1264. [Google Scholar] [CrossRef]
- Liu, P.; Cai, Y.; Zhang, J.; Wang, R.; Li, B.; Weng, Q.; Chen, Q. Antifungal activity of liquiritin in Phytophthora capsici comprises not only membrane-damage-mediated autophagy, apoptosis, and Ca2+ reduction but also an induced defense responses in pepper. Ecotoxicol. Environ. Saf. 2021, 209, 111813. [Google Scholar] [CrossRef]
- Barchenger, D.W.; Lamour, K.H.; Bosland, P.W. Challenges and strategies for breeding resistance in Capsicum annuum to the multifarious pathogen, Phytophthora capsici. Front. Plant Sci. 2018, 9, 628. [Google Scholar] [CrossRef]
- Wu, J.; Xue, Z.; Miao, J.; Zhang, F.; Gao, X.; Liu, X. Sensitivity of different developmental stages and resistance risk assessment of Phytophthora capsici to fluopicolide in China. Front. Microbiol. 2020, 11, 185. [Google Scholar] [CrossRef]
- Wang, W.; Liu, X.; Han, T.; Li, K.; Qu, Y.; Gao, Z. Differential potential of Phytophthora capsici resistance mechanisms to the fungicide metalaxyl in peppers. Microorganisms 2020, 8, 278. [Google Scholar] [CrossRef]
- Hunter, S.; Williams, N.; McDougal, R.; Scott, P.; Garbelotto, M. Evidence for rapid adaptive evolution of tolerance to chemical treatments in Phytophthora species and its practical implications. PLoS ONE 2018, 13, e0208961. [Google Scholar] [CrossRef] [PubMed]
- Lim, S.M.; Yoon, M.-Y.; Choi, G.J.; Choi, Y.H.; Jang, K.S.; Shin, T.S.; Park, H.W.; Yu, N.H.; Kim, Y.H.; Kim, J.-C. Diffusible and volatile antifungal compounds produced by an antagonistic Bacillus velezensis G341 against various phytopathogenic fungi. Plant Pathol. J. 2017, 33, 488. [Google Scholar] [CrossRef] [PubMed]
- Rajer, F.U.; Wu, H.; Xie, Y.; Xie, S.; Raza, W.; Tahir, H.A.S.; Gao, X. Volatile organic compounds produced by a soil-isolate, Bacillus subtilis FA26 induce adverse ultra-structural changes to the cells of Clavibacter michiganensis ssp. sepedonicus, the causal agent of bacterial ring rot of potato. Microbiology 2017, 163, 523–530. [Google Scholar] [CrossRef] [PubMed]
- Jaaffar, A.K.M.; Parejko, J.A.; Paulitz, T.C.; Weller, D.M.; Thomashow, L.S. Sensitivity of Rhizoctonia isolates to phenazine-1-carboxylic acid and biological control by phenazine-producing Pseudomonas spp. Phytopathology 2017, 107, 692–703. [Google Scholar] [CrossRef] [PubMed]
- Sheikh, T.M.M.; Zhou, D.; Haider, M.S.; Hussain, S.; Wang, N.; Chen, S.; Zhao, Y.; Wen, X.; Feng, H.; Wang, X. Volatile organic compounds from Pythium oligandrum play a role in its parasitism on plant-pathogenic Pythium myriotylum. Appl. Environ. Microbiol. 2023, 89, e02036-22. [Google Scholar] [CrossRef]
- González, M.S.; Diamont, D.; Gutiérrez, B. Técnica de tinción de estructuras fúngicas con colorantes vegetales como una alternativa no contaminante. Bioagro 2011, 23, 65–68. [Google Scholar]
- Li, Y.; Feng, X.; Wang, X.; Zheng, L.; Liu, H. Inhibitory effects of Bacillus licheniformis BL06 on Phytophthora capsici in pepper by multiple modes of action. Biol. Control 2020, 144, 104210. [Google Scholar] [CrossRef]
- Padilla-Jiménez, S.M.; Angoa-Pérez, M.V.; Mena-Violante, H.G.; Oyoque-Salcedo, G.; Montañez-Soto, J.L.; Oregel-Zamudio, E. Identification of organic volatile markers associated with aroma during maturation of strawberry fruits. Molecules 2021, 26, 504. [Google Scholar] [CrossRef]
- Syed-Ab-Rahman, S.F.; Carvalhais, L.C.; Chua, E.T.; Chung, F.Y.; Moyle, P.M.; Eltanahy, E.G.; Schenk, P.M. Soil bacterial diffusible and volatile organic compounds inhibit Phytophthora capsici and promote plant growth. Sci. Total Environ. 2019, 692, 267–280. [Google Scholar] [CrossRef]
- Montejano-Ramírez, V.; Ávila-Oviedo, J.L.; Campos-Mendoza, F.J.; Valencia-Cantero, E. Microbial Volatile Organic Compounds: Insights into Plant Defense. Plants 2024, 13, 2013. [Google Scholar] [CrossRef]
- Emanuel, R.-V.; César Arturo, P.-U.; Lourdes Iveth, M.-R.; Homero, R.d.l.C.; Mauricio Nahuam, C.-A. In vitro growth of Colletotrichum gloeosporioides is affected by butyl acetate, a compound produced during the co-culture of Trichoderma sp. and Bacillus subtilis. 3 Biotech 2020, 10, 329. [Google Scholar] [CrossRef] [PubMed]
- Henson, J.M.; Butler, M.J.; Day, A.W. The dark side of the mycelium: Melanins of phytopathogenic fungi. Annu. Rev. Phytopathol. 1999, 37, 447–471. [Google Scholar] [CrossRef] [PubMed]
- Sharma, M.; Schmid, M.; Rothballer, M.; Hause, G.; Zuccaro, A.; Imani, J.; Kämpfer, P.; Domann, E.; Schäfer, P.; Hartmann, A. Detection and identification of bacteria intimately associated with fungi of the order Sebacinales. Cell. Microbiol. 2008, 10, 2235–2246. [Google Scholar] [CrossRef] [PubMed]
- Ezrari, S.; Mhidra, O.; Radouane, N.; Tahiri, A.; Polizzi, G.; Lazraq, A.; Lahlali, R. Potential role of rhizobacteria isolated from citrus rhizosphere for biological control of citrus dry root rot. Plants 2021, 10, 872. [Google Scholar] [CrossRef]
- Bastías, D.A.; Johnson, L.J.; Card, S.D. Symbiotic bacteria of plant-associated fungi: Friends or foes? Curr. Opin. Plant Biol. 2020, 56, 1–8. [Google Scholar] [CrossRef]
- Garzón, C.D.; Molineros, J.E.; Yánez, J.M.; Flores, F.J.; del Mar Jiménez-Gasco, M.; Moorman, G.W. Sublethal doses of mefenoxam enhance Pythium damping-off of geranium. Plant Dis. 2011, 95, 1233–1238. [Google Scholar] [CrossRef]
- Zhang, M.; Li, J.; Shen, A.; Tan, S.; Yan, Z.; Yu, Y.; Xue, Z.; Tan, T.; Zeng, L. Isolation and identification of Bacillus amyloliquefaciens IBFCBF-1 with potential for biological control of phytophthora blight and growth promotion of pepper. J. Phytopathol. 2016, 164, 1012–1021. [Google Scholar] [CrossRef]
- Zohara, F.; Akanda, M.A.M.; Paul, N.C.; Rahman, M.; Islam, M.T. Inhibitory effects of Pseudomonas spp. on plant pathogen Phytophthora capsici in vitro and in planta. Biocatal. Agric. Biotechnol. 2016, 5, 69–77. [Google Scholar] [CrossRef]
- Hatano, E.; Hashidoko, Y.; Deora, A.; Fukushi, Y.; Tahara, S. Isolation and structure elucidation of peronosporomycetes hyphal branching-inducing factors produced by Pseudomonas jessenii EC-S101. Biosci. Biotechnol. Biochem. 2007, 71, 1601–1605. [Google Scholar] [CrossRef]
- Riquelme, M.; Aguirre, J.; Bartnicki-García, S.; Braus, G.H.; Feldbrügge, M.; Fleig, U.; Hansberg, W.; Herrera-Estrella, A.; Kämper, J.; Kück, U. Fungal morphogenesis, from the polarized growth of hyphae to complex reproduction and infection structures. Microbiol. Mol. Biol. Rev. 2018, 82, e00068-17. [Google Scholar] [CrossRef]
- Medina-Romero, Y.M.; Roque-Flores, G.; Macías-Rubalcava, M.L. Volatile organic compounds from endophytic fungi as innovative postharvest control of Fusarium oxysporum in cherry tomato fruits. Appl. Microbiol. Biotechnol. 2017, 101, 8209–8222. [Google Scholar] [CrossRef] [PubMed]
- Caulier, S.; Nannan, C.; Gillis, A.; Licciardi, F.; Bragard, C.; Mahillon, J. Overview of the antimicrobial compounds produced by members of the Bacillus subtilis group. Front. Microbiol. 2019, 10, 302. [Google Scholar] [CrossRef] [PubMed]
- Westhoff, S.; van Wezel, G.P.; Rozen, D.E. Distance-dependent danger responses in bacteria. Curr. Opin. Microbiol. 2017, 36, 95–101. [Google Scholar] [CrossRef] [PubMed]
- Simonetti, E.; Hernandez, A.I.; Kerber, N.L.; Pucheu, N.L.; Carmona, M.A.; Garcia, A.F. Protection of canola (Brassica napus) against fungal pathogens by strains of biocontrol rhizobacteria. Biocontrol Sci. Technol. 2012, 22, 111–115. [Google Scholar] [CrossRef]
- Kong, W.-L.; Li, P.-S.; Wu, X.-Q.; Wu, T.-Y.; Sun, X.-R. Forest tree associated bacterial diffusible and volatile organic compounds against various phytopathogenic fungi. Microorganisms 2020, 8, 590. [Google Scholar] [CrossRef]
- Ouhaibi-Ben Abdeljalil, N.; Vallance, J.; Gerbore, J.; Rey, P.; Daami-Remadi, M. Bio-suppression of Sclerotinia stem rot of tomato and biostimulation of plant growth using tomato-associated rhizobacteria. J. Plant Pathol. Microbiol. 2016, 7, 1000331. [Google Scholar] [CrossRef]
- Sánchez-Fernández, R.E.; Diaz, D.; Duarte, G.; Lappe-Oliveras, P.; Sánchez, S.; Macías-Rubalcava, M.L. Antifungal volatile organic compounds from the endophyte Nodulisporium sp. strain GS4d2II1a: A qualitative change in the intraspecific and interspecific interactions with Pythium aphanidermatum. Microb. Ecol. 2016, 71, 347–364. [Google Scholar] [CrossRef]
- Wang, J.; Mei, X.; Wei, Z.; Raza, W.; Shen, Q. Effect of bacterial intra-species community interactions on the production and activity of volatile organic compounds. Soil Ecol. Lett. 2021, 3, 32–41. [Google Scholar] [CrossRef]
- Preston, R.; Douthit, H. Germination of Bacillus cereus spores: Critical control by DL-alanine racemase. Microbiology 1984, 130, 3123–3133. [Google Scholar] [CrossRef]
- Song, G.C.; Ryu, C.-M. Two volatile organic compounds trigger plant self-defense against a bacterial pathogen and a sucking insect in cucumber under open field conditions. Int. J. Mol. Sci. 2013, 14, 9803–9819. [Google Scholar] [CrossRef]
- Kong, H.G.; Shin, T.S.; Kim, T.H.; Ryu, C.-M. Stereoisomers of the bacterial volatile compound 2, 3-butanediol differently elicit systemic defense responses of pepper against multiple viruses in the field. Front. Plant Sci. 2018, 9, 90. [Google Scholar] [CrossRef] [PubMed]
- Yi, H.-S.; Yang, J.W.; Ryu, C.-M. ISR meets SAR outside: Additive action of the endophyte Bacillus pumilus INR7 and the chemical inducer, benzothiadiazole, on induced resistance against bacterial spot in field-grown pepper. Front. Plant Sci. 2013, 4, 122. [Google Scholar] [CrossRef] [PubMed]
- Chávez-Avilés, M.N.; García-Álvarez, M.; Ávila-Oviedo, J.L.; Hernández-Hernández, I.; Bautista-Ortega, P.I.; Macías-Rodríguez, L.I. Volatile Organic Compounds Produced by Trichoderma asperellum with Antifungal Properties against Colletotrichum acutatum. Microorganisms 2024, 12, 2007. [Google Scholar] [CrossRef] [PubMed]
- Kigathi, R.N.; Unsicker, S.B.; Reichelt, M.; Kesselmeier, J.; Gershenzon, J.; Weisser, W.W. Emission of volatile organic compounds after herbivory from Trifolium pratense (L.) under laboratory and field conditions. J. Chem. Ecol. 2009, 35, 1335–1348. [Google Scholar] [CrossRef]
- Mavrodi, D.V.; Mavrodi, O.V.; Parejko, J.A.; Weller, D.M.; Thomashow, L.S. The role of 2, 4-diacetylphloroglucinol-and phenazine-1-carboxylic acid-producing Pseudomonas spp. in natural protection of wheat from soilborne pathogens. In Bacteria in Agrobiology: Plant Nutrient Management; Springer: Berlin/Heidelberg, Germany, 2011; pp. 267–283. [Google Scholar]
- Pang, Z.; Chong, J.; Li, S.; Xia, J. MetaboAnalystR 3.0: Toward an optimized workflow for global metabolomics. Metabolites 2020, 10, 186. [Google Scholar] [CrossRef]

| Relative Abundance (%) | |||||||
|---|---|---|---|---|---|---|---|
| # | RT | Compound | Pc | BMBH | BMBA | BMBC | BMBI |
| 1 | 3.2 | Isobutane | nd | 29.98 ± 1.20 | nd | nd | 9.18 ± 0.37 |
| 2 | 4.5 | Dimethyl ether | 22.07 ± 0.66 | 1.96 ± 0.06 | nd | nd | 4.14 ± 0.17 |
| 3 | 5.0 | Fluoroethylene | 57.84 ± 2.31 | 1.45 ± 0.04 | 0.37 ± 0.01 | 1.45 ± 0.06 | nd |
| 4 | 6.2 | 2-Pentanamine | 3.49 ± 0.12 | nd | nd | nd | nd |
| 5 | 6.8 | N-Methyl-1-octanamine | 3.51 ± 0.14 | nd | nd | nd | nd |
| 6 | 7.5 | Ethyl acetate | 0.44 ± 0.02 | nd | nd | nd | nd |
| 7 | 8.0 | Cyclopropyl carbinol | 9.23 ± 0.28 | nd | nd | nd | nd |
| 8 | 10.5 | 2-Nitropropane | nd | 0.27 ± 0.01 | 0.18 ± 0.01 | nd | nd |
| 9 | 12.0 | 4-Methyl-2,4,6-tri-tert-butylcyclohexane-2,5-dien-1-one | 0.36 ± 0.01 | nd | 0.17 ± 0.01 | 0.58 ± 0.02 | nd |
| 10 | 13.2 | 3-Methyl-1-butanol | nd | 5.20 ± 0.21 | nd | nd | 6.45 ± 0.26 |
| 11 | 13.5 | 2-Methyl-1-butanol | nd | 26.80 ± 1.07 | nd | nd | 5.64 ± 0.23 |
| 12 | 14.0 | 4-Penten-2-ol | nd | 28.03 ± 1.12 | 0.60 ± 0.02 | nd | nd |
| 13 | 15.5 | DL-Alanine | nd | 4.33 ± 0.17 | nd | nd | 6.74 ± 0.27 |
| 14 | 16.8 | 1-Methoxy-2-methyl-2-propanol | nd | nd | 16.29 ± 0.65 | nd | nd |
| 15 | 17.2 | 2-Nitroethanol | nd | nd | nd | nd | 5.05 ± 0.20 |
| 16 | 17.5 | 1-Pentanal | nd | nd | nd | nd | 1.72 ± 0.07 |
| 17 | 18.0 | 2,3-Butanedione | nd | nd | 0.28 ± 0.01 | 1.65 ± 0.07 | nd |
| 18 | 18.3 | Methyl acrylate | nd | nd | 1.21 ± 0.05 | 3.04 ± 0.12 | nd |
| 19 | 19.0 | Methylglyoxal | nd | nd | 12.29 ± 0.49 | nd | nd |
| 20 | 20.5 | Acetoin | nd | nd | 25.91 ± 1.04 | 35.51 ± 1.42 | nd |
| 21 | 21.0 | L-Lactic acid | nd | nd | 16.42 ± 0.66 | 13.18 ± 0.53 | 25.31 ± 1.01 |
| 22 | 22.0 | Methyltartronic acid | nd | nd | 21.64 ± 0.87 | nd | 32.70 ± 1.31 |
| 23 | 23.5 | Hydrazoic acid | nd | nd | 1.09 ± 0.04 | 0.68 ± 0.03 | nd |
| 24 | 24.0 | Methylhydrazine | nd | nd | nd | 6.03 ± 0.24 | nd |
| 25 | 25.0 | 5-Amino-6-nitrosopyrimidine-2,4(1H,3H)-dione | nd | nd | 0.74 ± 0.03 | 3.12 ± 0.12 | nd |
| 26 | 26.5 | Chloromethyl methyl ether | nd | nd | 0.99 ± 0.04 | 9.61 ± 0.38 | nd |
| 27 | 27.0 | Acetic anhydride | nd | nd | 1.39 ± 0.06 | 4.44 ± 0.18 | nd |
| 28 | 27.5 | Ketene | nd | nd | nd | 0.29 ± 0.01 | nd |
| 29 | 28.0 | Butylated hydroxytoluene | nd | nd | 0.35 ± 0.01 | 0.45 ± 0.02 | nd |
| 30 | 29.0 | 2,2′,6,6′-Tetra-tert-butyl-4,4′-dimethyl-4H,4′H-4,4′-bipyran | nd | nd | nd | nd | 2.43 ± 0.10 |
| 31 | 30.0 | Eicosane | 3.06 ± 0.15 | nd | nd | nd | nd |
| 32 | 31.5 | Ethyl methoxyacetate | nd | nd | nd | 19.14 ± 0.77 | Nd |
| Relative Abundance (%) | ||||||
|---|---|---|---|---|---|---|
| # | RT | Compound | BMBA/Pc | BMBC/Pc | BMBH/Pc | BMBI/Pc |
| 1 | 3.2 | Isobutane | nd | nd | 28.04 ± 1.05 | 16.25 ± 0.65 |
| 2 | 4.5 | Dimethyl ether | nd | 2.78 ± 0.11 | 2.33 ± 0.08 | nd |
| 3 | 5.0 | Fluoroethylene | 0.18 ± 0.007 | nd | nd | nd |
| 4 | 6.2 | 2-Pentanamine | nd | nd | nd | nd |
| 5 | 6.8 | N-Methyl-1-octanamine | nd | nd | nd | nd |
| 6 | 7.5 | Ethyl acetate | nd | nd | nd | 13.42 ± 0.55 |
| 7 | 8.0 | Cyclopropyl carbinol | 0.06 ± 0.002 | nd | nd | nd |
| 8 | 10.5 | 2-Nitropropane | nd | 0.51 ± 0.02 | nd | nd |
| 9 | 12.0 | 4-Methyl-2,4,6-tri-tert-butylcyclohexane-2,5-dien-1-one | 0.08 ± 0.003 | 0.28 ± 0.012 | nd | 5.48 ± 0.22 |
| 10 | 13.2 | 3-Methyl-1-butanol | nd | nd | 17.39 ± 0.70 | 6.19 ± 0.25 |
| 11 | 13.5 | 2-Methyl-1-butanol | nd | nd | nd | 6.56 ± 0.27 |
| 12 | 14.0 | 4-Penten-2-ol | 1.07 ± 0.04 | nd | nd | nd |
| 13 | 15.5 | DL-Alanine | nd | nd | 9.57 ± 0.38 | 4.10 ± 0.17 |
| 14 | 16.8 | 1-Methoxy-2-methyl-2-propanol | nd | 17.45 ± 0.70 | nd | nd |
| 15 | 17.2 | 2-Nitroethanol | nd | nd | 27.88 ± 1.10 | 19.38 ± 0.80 |
| 16 | 17.5 | 1-Pentanal | nd | nd | 8.08 ± 0.30 | nd |
| 17 | 18.0 | 2,3-Butanedione | 1.20 ± 0.05 | 3.01 ± 0.12 | nd | nd |
| 18 | 18.3 | Methyl acrylate | 1.97 ± 0.08 | 1.17 ± 0.05 | nd | nd |
| 19 | 19.0 | Methylglyoxal | 1.88 ± 0.08 | nd | nd | nd |
| 20 | 20.5 | Acetoin | 44.53 ± 1.80 | 20.06 ± 0.80 | 1.46 ± 0.06 | nd |
| 21 | 21.0 | L-Lactic acid | 2.51 ± 0.10 | 32.78 ± 1.30 | nd | nd |
| 22 | 22.0 | Methyltartronic acid | 2.13 ± 0.08 | nd | nd | nd |
| 23 | 23.5 | Hydrazoic acid | 0.26 ± 0.01 | nd | nd | 19.57 ± 0.80 |
| 24 | 24.0 | Methylhydrazine | nd | nd | nd | 5.41 ± 0.22 |
| 25 | 25.0 | 5-Amino-6-nitrosopyrimidine-2,4(1H,3H)-dione | nd | nd | nd | nd |
| 26 | 26.5 | Chloromethyl methyl ether | 14.64 ± 0.60 | nd | nd | nd |
| 27 | 27.0 | Acetic anhydride | 2.03 ± 0.08 | 1.74 ± 0.07 | nd | nd |
| 28 | 27.5 | Ketene | 1.20 ± 0.05 | 0.12 ± 0.005 | nd | nd |
| 29 | 28.0 | Butylated hydroxytoluene | nd | nd | nd | nd |
| 30 | 29.0 | 2,2′,6,6′-Tetra-tert-butyl-4,4′-dimethyl-4H,4′H-4,4′-bipyran | nd | nd | 1.76 ± 0.07 | nd |
| 31 | 30.0 | Eicosane | nd | nd | 3.47 ± 0.14 | nd |
| 32 | 31.5 | Ethyl methoxyacetate | 26.19 ± 1.00 | 20.06 ± 0.80 | nd | nd |
Disclaimer/Publisher’s Note: The statements, opinions and data contained in all publications are solely those of the individual author(s) and contributor(s) and not of MDPI and/or the editor(s). MDPI and/or the editor(s) disclaim responsibility for any injury to people or property resulting from any ideas, methods, instructions or products referred to in the content. |
© 2024 by the authors. Licensee MDPI, Basel, Switzerland. This article is an open access article distributed under the terms and conditions of the Creative Commons Attribution (CC BY) license (https://creativecommons.org/licenses/by/4.0/).
Share and Cite
Ávila-Oviedo, J.L.; Méndez-Inocencio, C.; Rodríguez-Torres, M.D.; Angoa-Pérez, M.V.; Chávez-Avilés, M.N.; Martínez-Mendoza, E.K.; Oregel-Zamudio, E.; Villar-Luna, E. Antagonistic Effects and Volatile Organic Compound Profiles of Rhizobacteria in the Biocontrol of Phytophthora capsici. Plants 2024, 13, 3224. https://doi.org/10.3390/plants13223224
Ávila-Oviedo JL, Méndez-Inocencio C, Rodríguez-Torres MD, Angoa-Pérez MV, Chávez-Avilés MN, Martínez-Mendoza EK, Oregel-Zamudio E, Villar-Luna E. Antagonistic Effects and Volatile Organic Compound Profiles of Rhizobacteria in the Biocontrol of Phytophthora capsici. Plants. 2024; 13(22):3224. https://doi.org/10.3390/plants13223224
Chicago/Turabian StyleÁvila-Oviedo, José Luis, Carlos Méndez-Inocencio, María Dolores Rodríguez-Torres, María Valentina Angoa-Pérez, Mauricio Nahuam Chávez-Avilés, Erika Karina Martínez-Mendoza, Ernesto Oregel-Zamudio, and Edgar Villar-Luna. 2024. "Antagonistic Effects and Volatile Organic Compound Profiles of Rhizobacteria in the Biocontrol of Phytophthora capsici" Plants 13, no. 22: 3224. https://doi.org/10.3390/plants13223224
APA StyleÁvila-Oviedo, J. L., Méndez-Inocencio, C., Rodríguez-Torres, M. D., Angoa-Pérez, M. V., Chávez-Avilés, M. N., Martínez-Mendoza, E. K., Oregel-Zamudio, E., & Villar-Luna, E. (2024). Antagonistic Effects and Volatile Organic Compound Profiles of Rhizobacteria in the Biocontrol of Phytophthora capsici. Plants, 13(22), 3224. https://doi.org/10.3390/plants13223224








